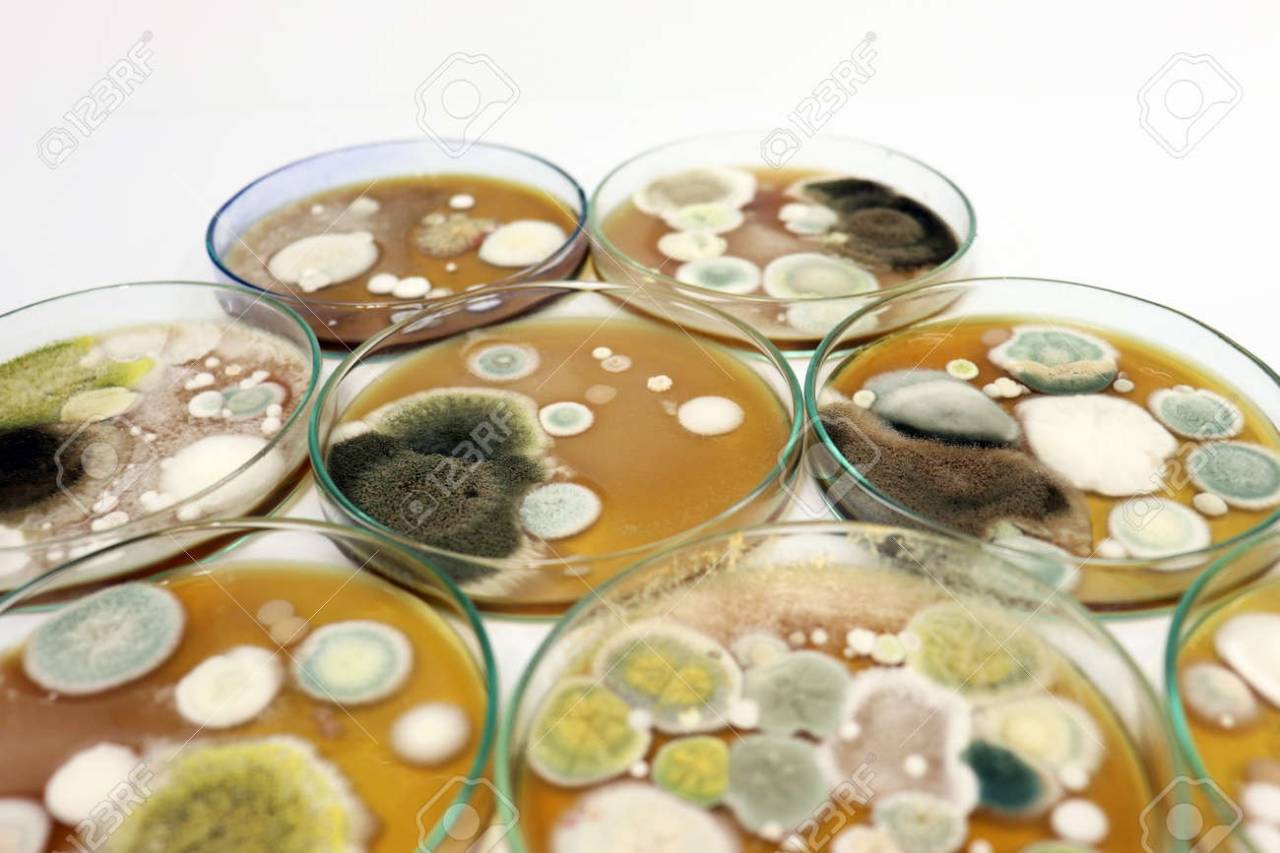

健康被害の裏に潜む「カビ」の正体とは?耐性真菌のニュースから考える、見えない室内リスクと正しい対策の重要性
2026/01/16
健康被害の裏に潜む「カビ」の正体とは?耐性真菌のニュースから考える、見えない室内リスクと正しい対策の重要性
咳・喘息・アレルギーの原因は空気中のカビ?耐性を持つ真菌が注目される今、住環境を見直すべき理由
こんにちは😊
MIST工法®カビバスターズ本部のブログをご覧いただきありがとうございます✨
最近、「原因不明の咳が続く」「喘息やアレルギーが悪化した気がする」「空気がなんとなく重い…」と感じて検索される方が増えています。実はその背景には、**室内に潜むカビ(真菌)**が関係しているケースが少なくありません。
さらに近年、ニュースや医療分野で話題になっているのが、**抗真菌薬に耐性を持つカビ(耐性真菌)**の存在です。特に Aspergillus fumigatus(アスペルギルス・フミガタス) などは、環境中に広く存在し、免疫力が低下している方だけでなく、健康な方にも影響を及ぼす可能性があるとして注目されています。
現代の住宅は高気密・高断熱が進み、快適な反面、一度湿気や水分トラブルが起きると、カビが見えない場所で増殖しやすい構造になっています。表面を掃除しても再発を繰り返すのは、「原因そのもの」が建材内部や壁の中、空気の流れに隠れているからです。
MIST工法®カビバスターズでは、日本全国のカビトラブルに対応し、「なぜカビが発生したのか?」という原因追究を最重視しています。
そのため、一般社団法人微生物対策協会と連携した真菌(カビ菌)検査をはじめ、
・室内建材の含水率検査
・ファイバースコープによる壁内調査
・風量計を使った負圧検査
など、目に見えない部分まで丁寧に確認します🔍
「健康への影響が心配」「どこに相談すればいいかわからない」
そんな時こそ、無理に自己判断せず、手に負えないカビトラブルはMIST工法®カビバスターズ本部へご相談ください。
このブログでは、難しい専門用語を使わず、誰でも理解できる形でカビと健康の関係をお伝えしていきます🌸
目次
なぜ今「カビ」が健康不安として注目されているのか?
咳・喘息・アレルギーの裏にある見えない原因と、ニュースで話題の耐性真菌
最近、インターネット検索で
「咳が続く カビ」
「喘息 カビ 影響」
「アレルギー 室内環境」
といった言葉を目にする機会が増えていませんか?🤔
その背景には、室内のカビが健康不安の原因になり得るという認識が、少しずつ広まってきたことがあります。カビは見た目が黒く目立つものだけでなく、目に見えない胞子として空気中を漂い、呼吸とともに体内へ入り込む存在です。
特に、
✔ 原因不明の咳が長引く
✔ 喘息の症状が悪化した
✔ アレルギー症状が季節に関係なく出る
こうしたケースでは、住環境に潜むカビが関係している可能性があります。
さらに近年、ニュースや医療分野で注目されているのが、**抗真菌薬に耐性を持つカビ(耐性真菌)**の存在です。これまで「環境中に普通にいるだけ」と思われていたカビが、治療が難しい問題として扱われるようになったことで、「自宅のカビは大丈夫なの?」と不安を感じる方が急増しています📈
また、気候変動による
・高温多湿な環境
・集中豪雨や結露の増加
・住宅の高気密・高断熱化
といった要因も重なり、カビが発生・拡大しやすい条件がそろっているのが現代の住まいの特徴です。
つまり今、「カビ」が検索されている理由は、
👉 見た目の問題ではなく
👉 健康への影響が現実的なリスクとして意識され始めたから。
体調不良の原因がはっきりしない時こそ、室内環境を疑ってみることが大切です。
次の章では、室内のカビが私たちの体にどのような影響を与えるのかを、さらにわかりやすく解説していきます😊
室内のカビが体に与える影響をわかりやすく解説
空気中に漂うカビ胞子が、知らないうちに体へ入り込んでいる?
「カビって、見えたら掃除すればいいものじゃないの?」
そう思われる方はとても多いです😊
しかし実は、健康への影響という点では“見えないカビ”の方が問題になることが少なくありません。
カビは成長すると、非常に小さな胞子を空気中に放出します。この胞子は目に見えず、ホコリと一緒に室内を漂い、私たちが呼吸をするたびに鼻や喉、肺へと入り込む可能性があります。
その結果、
・喉のイガイガ
・長引く咳
・鼻水やくしゃみ
・喘息症状の悪化
・アレルギー反応
といった症状が現れることがあります😷
特に、小さなお子さまや高齢の方、アレルギー体質の方は影響を受けやすいといわれています。
ここで大切なのは、**「免疫力が低い人だけの問題ではない」**という点です。
健康な方でも、
✔ 室内にカビが多い状態
✔ 換気がうまくいっていない
✔ 湿気がこもりやすい住環境
が重なると、知らないうちに体へ負担がかかっているケースがあります。
また、最近注目されている耐性真菌の話題もあり、
「昔よりカビの影響が強くなっているのでは?」
「環境の変化でカビの性質が変わってきているのでは?」
と不安に感じる方が増えているのも事実です。
さらに厄介なのが、体調不良とカビの関係に気づきにくいこと。
風邪や花粉症、年齢のせいだと思い込み、住まいが原因だとは考えないまま時間が過ぎてしまうケースも多いのです。
だからこそ、
「最近、家にいると体調がすぐれない」
「外出すると少し楽になる」
と感じる方は、室内環境を見直すサインかもしれません🏠
次の章では、近年ニュースでも取り上げられる
「耐性真菌(アゾール耐性)」がなぜ問題視されているのかについて、
専門知識がなくても理解できるように解説していきます😊
耐性真菌(アゾール耐性)が問題視される理由
「普通のカビ」ではなくなってきている?医療・環境の両面から注目される新たなリスク
最近、ニュースや医療関連記事で
「耐性真菌」
「アゾール耐性」
といった言葉を見かける機会が増えてきました📰
「なんだか難しそう…」と感じるかもしれませんが、実は私たちの身近な住環境とも無関係ではありません。
耐性真菌とは、簡単に言うと、
👉 抗真菌薬(カビを抑える薬)が効きにくくなったカビ
のことです。
特に注目されているのが、空気中や土壌、建物の中など、自然界に広く存在するカビの一種です。これらは以前から身近な存在でしたが、近年、薬に対する耐性を持つタイプが増えていることが問題視されています。
なぜ、このような変化が起きているのでしょうか?
背景には、
・農業分野で使われる防カビ剤
・都市化による環境変化
・地球温暖化による高温多湿化
といった、人間の生活と環境の変化が影響していると考えられています🌏
ここで大切なのは、
「耐性真菌=病院の話」
では終わらないという点です。
これらのカビは、屋外だけでなく室内環境にも入り込みやすいため、
・換気が不十分
・湿気がこもる
・結露や水漏れがある
といった住宅条件がそろうと、住まいの中で増殖するリスクも高まります。
また、耐性真菌が注目されることで、
「カビは拭けば終わり」
「見えなければ大丈夫」
という従来の考え方では、不十分な時代になってきていることが明らかになってきました。
特に、体調不良やアレルギー症状がある場合、
「どんな種類のカビが、どの程度存在しているのか」
を把握せずに放置することは、健康面でも住環境面でも不安が残ります😥
だからこそ今、
✔ カビの“量”だけでなく
✔ カビの“種類”にも目を向ける
という考え方が重要になっています。
次の章では、こうした耐性真菌を含め、
住宅のどこで、どのようにカビが広がっているのか
「見えない場所」に焦点を当てて、わかりやすく解説していきます😊
見えていない場所に広がる住宅内カビの実態
「見えないから大丈夫」は危険信号?カビは静かに、確実に広がっていきます
カビというと、
「お風呂の黒い汚れ」
「窓まわりの結露カビ」
を思い浮かべる方が多いかもしれません🛁
ですが、実際に**健康や再発トラブルにつながりやすいのは“見えていない場所のカビ”**です。
住宅の中で特に注意が必要なのは、
・壁の中
・天井裏
・床下
・収納の奥
・建材の内部
といった、普段目にすることのない空間です。
ここでは空気の流れが悪く、湿気が逃げにくいため、カビにとって非常に居心地のよい環境が整いやすくなります。
現代の住宅は、
✔ 高気密
✔ 高断熱
✔ 省エネ設計
が進んでいる一方で、
一度、
・結露
・雨漏り
・配管トラブル
・生活湿気の滞留
が起きると、内部に水分が残りやすい構造になっています。
この「残った水分」こそが、カビ発生の大きな原因です💧
さらに厄介なのは、
👉 壁紙や床をきれいにしても
👉 中のカビはそのまま残っている
というケースが多いこと。
その結果、
「一度きれいになったのに、また同じ場所にカビが出る」
「別の部屋で同じような症状が出始めた」
といった再発トラブルにつながってしまいます。
このような状況では、
見た目だけで判断することはとても危険です。
本当に大切なのは、
「どこに湿気があり」
「なぜそこにカビが発生したのか」
という原因を突き止めること。
MIST工法®カビバスターズ本部では、
・室内建材の含水率を確認し
・ファイバースコープで壁の中を調査し
・風量計を用いて空気の流れ(負圧)を確認
することで、目に見えないカビの温床を見逃さない調査を重視しています🔍
「カビが見えない=安心」ではなく、
「見えないからこそ、調べる価値がある」
それが、現代の住まいにおけるカビ対策の基本です。
次の章では、
「なぜ掃除してもカビが再発してしまうのか?」
多くの方が悩む疑問について、原因の視点からわかりやすく解説していきます😊
「掃除しても再発する」その本当の原因
きれいにしたはずなのに、なぜ同じ場所にまたカビが出るの?
「一生懸命掃除したのに、数か月後またカビが…」
「市販のカビ取り剤を使ったのに、完全には消えなかった」
こうしたお悩みは、カビトラブルの中でも特に多いご相談です😥
実はこれ、決して珍しいことではありません。
その理由はとてもシンプルで、
👉 カビの“原因”が残ったままだから
です。
多くの方が行うカビ対策は、
・見えている部分を拭く
・黒ずみを落とす
・においを消す
といった表面の対処が中心です。
しかし、カビは
✔ 建材の奥
✔ 壁の内部
✔ 空気の流れが悪い場所
など、目に見えないところに根を張っていることが多く、
そこに
・湿気
・水分
・空気の滞留
が残っている限り、再び成長してしまいます🌱
特に現代の住宅では、
高気密・高断熱の影響で、
「湿気が逃げにくい」
「乾きにくい」
という特徴があります。
そのため、
✔ 結露が起きた
✔ 一度水漏れがあった
✔ 梅雨時期に湿度が高かった
といった出来事がきっかけで、建材内部に水分がとどまり続けるケースが少なくありません。
この状態を放置すると、見た目はきれいでも、内部ではカビが静かに生き続けているのです。
さらにもう一つの落とし穴が、空気の流れです。
室内が負圧状態になっていると、
・床下
・壁の中
・天井裏
から、カビ胞子を含んだ空気が室内に引き込まれることがあります。
この場合、掃除しても、別の場所から胞子が供給され続けるため、再発を繰り返してしまいます。
つまり、
「掃除しても再発するカビ」は、
👉 カビそのものより
👉 住まいの環境バランスの問題
であることが多いのです。
だからこそ重要なのが、
・どこに水分が残っているのか
・なぜ湿気がたまったのか
・空気はどう流れているのか
といった原因を一つひとつ確認すること。
原因改善を行わない限り、現代の建物では再発の可能性が非常に高いのが現実です。
次の章では、
こうした不安を「感覚」ではなく「根拠」で判断するための
真菌検査の重要性について、やさしく解説していきます😊
健康が気になる方にこそ知ってほしい「真菌検査」
「なんとなく不安」を「はっきりした判断材料」に変えるための大切な検査
「もしかしてカビが原因かも…?」
「でも、本当に関係があるのかわからない」
カビと健康の問題で多いのが、**この“はっきりしない不安”**です😟
見えない、においも強くない、でも体調はすぐれない――
このような状況では、自己判断がとても難しくなります。
そこで重要になるのが、**真菌検査(カビ菌検査)**という考え方です。
真菌検査とは、室内環境中に
・どんな種類の真菌(カビ菌)が
・どのくらい存在しているのか
を科学的に調べる検査です🔬
この検査を行うことで、
✔ カビが本当に存在しているのか
✔ 健康への影響が考えられるレベルなのか
✔ 生活環境として問題がないか
といった点を、感覚ではなく数値やデータで確認することができます。
特に、
・咳や喘息、アレルギー症状がある
・家にいると体調が悪くなる
・カビの再発を繰り返している
といった方にとって、
「原因が住環境にあるのかどうか」を見極めることは、とても大切な第一歩です。
MIST工法®カビバスターズ本部では、
一般社団法人微生物対策協会と連携し、
信頼性の高い真菌検査を重視しています。
これにより、
「目に見えないから放置」
「よくわからないから我慢」
といった状態から抜け出し、
👉 必要な対策を、必要な分だけ考える
ことが可能になります✨
また、真菌検査は
「大きなトラブルが起きてから」ではなく、
“少し気になる段階”で行うほど効果的です。
健康不安を抱えながら生活を続けるより、
まずは住環境の状態を知る。
それだけでも、気持ちがぐっと楽になる方は少なくありません😊
次の章では、
真菌検査とあわせて行われる
MIST工法®カビバスターズ本部の調査の考え方について、
「なぜそこまで調べるのか?」をやさしく解説していきます。
MIST工法®カビバスターズ本部が行う調査の考え方
「カビを取る前に、なぜ“原因”を徹底的に調べるのか?」
カビの相談を受ける中で、私たちが最も大切にしているのは、
「なぜ、そこにカビが発生したのか?」
という視点です。
カビは突然発生するものではありません。
必ず、
・水分
・湿気
・空気の流れ
・建物の構造
といった明確な原因があります。
この原因を見落としたままでは、どれだけ表面をきれいにしても、再発のリスクが高いのが現代の住宅の特徴です🏠
そこでMIST工法®カビバスターズ本部では、
「見える部分」だけで判断せず、
数値・機器・目視を組み合わせた調査を行います。
まず重要なのが、室内建材の含水率検査です。
壁や床、天井などの建材に、
「どれくらい水分が含まれているのか」
を測定することで、乾いているように見えて実は湿っている場所を見つけることができます。
この“隠れた水分”こそ、カビの温床になりやすいポイントです💧
次に行うのが、ファイバースコープを使った壁の中の調査です。
壁を壊さずに内部を確認できるため、
・カビの有無
・結露跡
・水染み
など、普段は絶対に見えない状態を直接確認できます🔍
「見て初めて納得できた」というお声も多く、原因究明には欠かせない調査です。
さらに、風量計を用いた負圧の検査も重要なポイントです。
室内が負圧状態になっていると、
床下や壁の中、天井裏から空気が引き込まれ、
カビ胞子を含んだ空気が室内に入り続けることがあります。
このような状態では、
いくら掃除しても、
いくら換気しても、
根本的な改善にはつながりません。
つまり、
✔ 水分の状態
✔ 見えない内部
✔ 空気の流れ
この3つをセットで確認してこそ、
「本当の原因」が見えてくるのです。
MIST工法®カビバスターズ本部は、
日本全国のカビトラブルに対応し、
再発させないための原因追究を最優先に考えています。
次の章では、
カビ問題を放置するとどうなるのか?
健康面・住宅面の両方から、知っておいてほしいリスクについて解説していきます😊
放置するとどうなる?カビ問題と再発リスク
「今は大丈夫」が一番危ない?カビを放置することで起こり得る影響
「少しカビはあるけど、生活できているから大丈夫」
「忙しくて後回しにしている」
このように、カビ問題はつい放置されがちです😥
しかし、カビは時間が経てば自然に消えることはなく、静かに、確実に影響を広げていく存在です。
まず心配されるのが、健康面への影響です。
カビは増殖する過程で胞子を放出し、空気中に広がります。
これを日常的に吸い込むことで、
・慢性的な咳
・喘息症状の悪化
・アレルギー反応
・喉や目の違和感
といった症状が、少しずつ強くなるケースがあります。
特に、ご家族に
✔ 小さなお子さま
✔ 高齢の方
✔ アレルギー体質の方
がいる場合、影響を受けやすいため注意が必要です。
次に見逃せないのが、住宅そのものへのダメージです。
カビは、
・木材
・石膏ボード
・断熱材
などを栄養源にして成長します。
放置すると、
「見た目はきれいでも、中は傷んでいる」
という状態になり、建材の劣化や性能低下につながることもあります🏠
さらに問題なのが、再発リスクの増大です。
原因を改善しないまま放置すると、
✔ 湿気がたまりやすい環境が続く
✔ カビが根を張ったまま残る
✔ 胞子が住宅内に広がる
という悪循環が起こり、
少しのきっかけで再び表面化してしまいます。
「何度も同じ場所にカビが出る」
「別の部屋にも広がってきた」
という状態は、放置のサインとも言えます。
カビ問題は、
👉 早く気づいて
👉 原因を知り
👉 適切に対応する
ほど、負担が少なく済むケースがほとんどです。
「様子を見る」よりも、「状態を知る」ことが、結果的に安心につながります😊
次の章では、
どんな症状や状況があれば要注意なのか
カビ問題を見逃さないためのチェックポイントを、わかりやすくご紹介します。
こんな症状・お悩みがあれば要注意
それ、体の問題ではなく「住まいからのサイン」かもしれません
カビの問題は、
「目に見える黒い汚れ」
だけで気づけるとは限りません。
むしろ多いのは、体調や暮らしの変化を通じて現れるサインです。
次のような症状やお悩みはありませんか?🤔
✔ 家にいると咳や喉の違和感が出る
✔ 外出すると少し楽になる
✔ 喘息やアレルギー症状が以前より悪化した
✔ 原因不明の鼻水・くしゃみが続く
✔ 家の中でカビ臭さを感じることがある
これらは、室内環境にカビが関係している可能性を示すサインです。
また、住まいの状態から気づくケースもあります。
✔ 窓やサッシの結露が多い
✔ 押し入れや収納の奥がジメジメする
✔ 壁紙が浮いたり、波打っている
✔ 床が冷たく湿っぽい
✔ 以前、水漏れや雨漏りがあった
こうした状況は、カビが発生しやすい環境が整っている証拠でもあります💧
特に注意したいのは、
「体調の変化」と「住まいの変化」が同時に起きている場合。
この場合、
「年齢のせい」
「体質だから」
と片付けてしまう前に、住環境を疑ってみる価値があります。
カビは、
👉 目に見えない
👉 においが弱いこともある
👉 少しずつ影響が出る
という特徴があるため、気づいた時には広がっているケースも少なくありません。
「これってカビ?」
「うちも当てはまるかも…」
そう感じた時点が、行動するベストタイミングです。
不安を抱えたまま我慢せず、
まずは状態を知ることが、安心への第一歩になります😊
次の章では、
手に負えないカビトラブルを、どこに相談すればいいのか
失敗しない相談先の考え方についてお伝えします。
手に負えないカビトラブルは早めの相談が安心
「まだ大丈夫」と思っている今こそ、相談する価値があります
カビを見つけたとき、
「とりあえず自分で何とかしよう」
「もう少し様子を見てから考えよう」
そう思う方はとても多いです🙂
もちろん、軽度で一時的なものであれば、ご自身で対処できる場合もあります。
しかし、
✔ 何度も同じ場所にカビが出る
✔ 範囲が少しずつ広がっている
✔ 健康への影響が気になっている
このような状況では、個人での対応には限界があります。
特に、壁の中や床下、天井裏など、見えない場所が関係しているカビは、
原因を把握しないまま対処すると、
「一時的にきれいになっただけ」
という結果になりがちです。
カビ問題で大切なのは、
👉 どこに相談するか
👉 どんな視点で見てもらうか
です。
MIST工法®カビバスターズ本部では、
日本全国のカビトラブルに対応し、
「取ること」よりも、「なぜ発生したのか」を明らかにすることを重視しています。
また、
・真菌検査による客観的な判断
・含水率検査による水分状態の確認
・ファイバースコープによる壁内調査
・風量計を使った空気の流れの確認
などを通じて、再発リスクを見逃さないための情報整理を行います🔍
「相談するほどでもないかも…」
と思っている段階こそ、実は一番大切なタイミングです。
小さな不安のうちに動くことで、
・健康面の安心
・住まいの安心
・将来的な負担の軽減
につながるケースが多くあります。
カビの問題は、
👉 我慢するもの
👉 放置するもの
ではありません。
正しく知り、正しく向き合うことで、安心できる住環境を取り戻すことができます😊
次はいよいよ最後の章、
まとめ:健康を守るために「知ること」から始めよう
をお届けします。
まとめ|健康を守るために「知ること」から始めよう
カビを正しく知ることが、家族と住まいの未来を守る第一歩
ここまでお読みいただき、ありがとうございます😊
今回のテーマである
「健康不安としてのカビ」
そして
**「耐性真菌が注目される理由」**は、決して特別な人だけの話ではありません。
現代の住宅は快適である一方、
・高気密・高断熱
・湿気がこもりやすい
・見えない場所に問題が起きやすい
という特徴を持っています。
その中でカビは、気づかれないまま増え、静かに影響を及ぼす存在です。
大切なのは、
「怖がりすぎること」ではなく、
👉 正しく知ること
👉 状態を把握すること
です。
✔ 体調の変化に気づいたとき
✔ 掃除しても再発を繰り返すとき
✔ 住まいに違和感を覚えたとき
それは、住環境を見直すサインかもしれません。
カビ問題は、
・真菌検査で見える化する
・含水率検査で水分状態を確認する
・ファイバースコープで壁の中を知る
・風量計で空気の流れを把握する
といった客観的な情報をもとに判断することが、安心への近道です🔍
MIST工法®カビバスターズ本部は、日本全国のカビトラブルに対応し、
手に負えないカビ問題や、原因がわからず不安を抱える方のご相談を受け付けています。
「これってカビ?」
「健康への影響が心配…」
「どこに相談すればいいかわからない」
そんなときは、一人で悩まず、ぜひご相談ください😊
住まいと健康は、毎日の生活の土台です。
知ること・調べることから、安心できる暮らしは始まります。
あなたとご家族が、心から安心できる住環境で過ごせますように🌸
今後もこのブログでは、カビ・住環境・健康について、
わかりやすく丁寧にお伝えしていきます。
------------------------------------------------------------------------------------------------------------------------
カビ取り・カビ対策専門業者MIST工法カビバスターズ本部
0120-052-127(平日9時から17時)
カビの救急箱
【検査機関】
一般社団法人微生物対策協会
------------------------------------------------------------------------------------------------------------------------